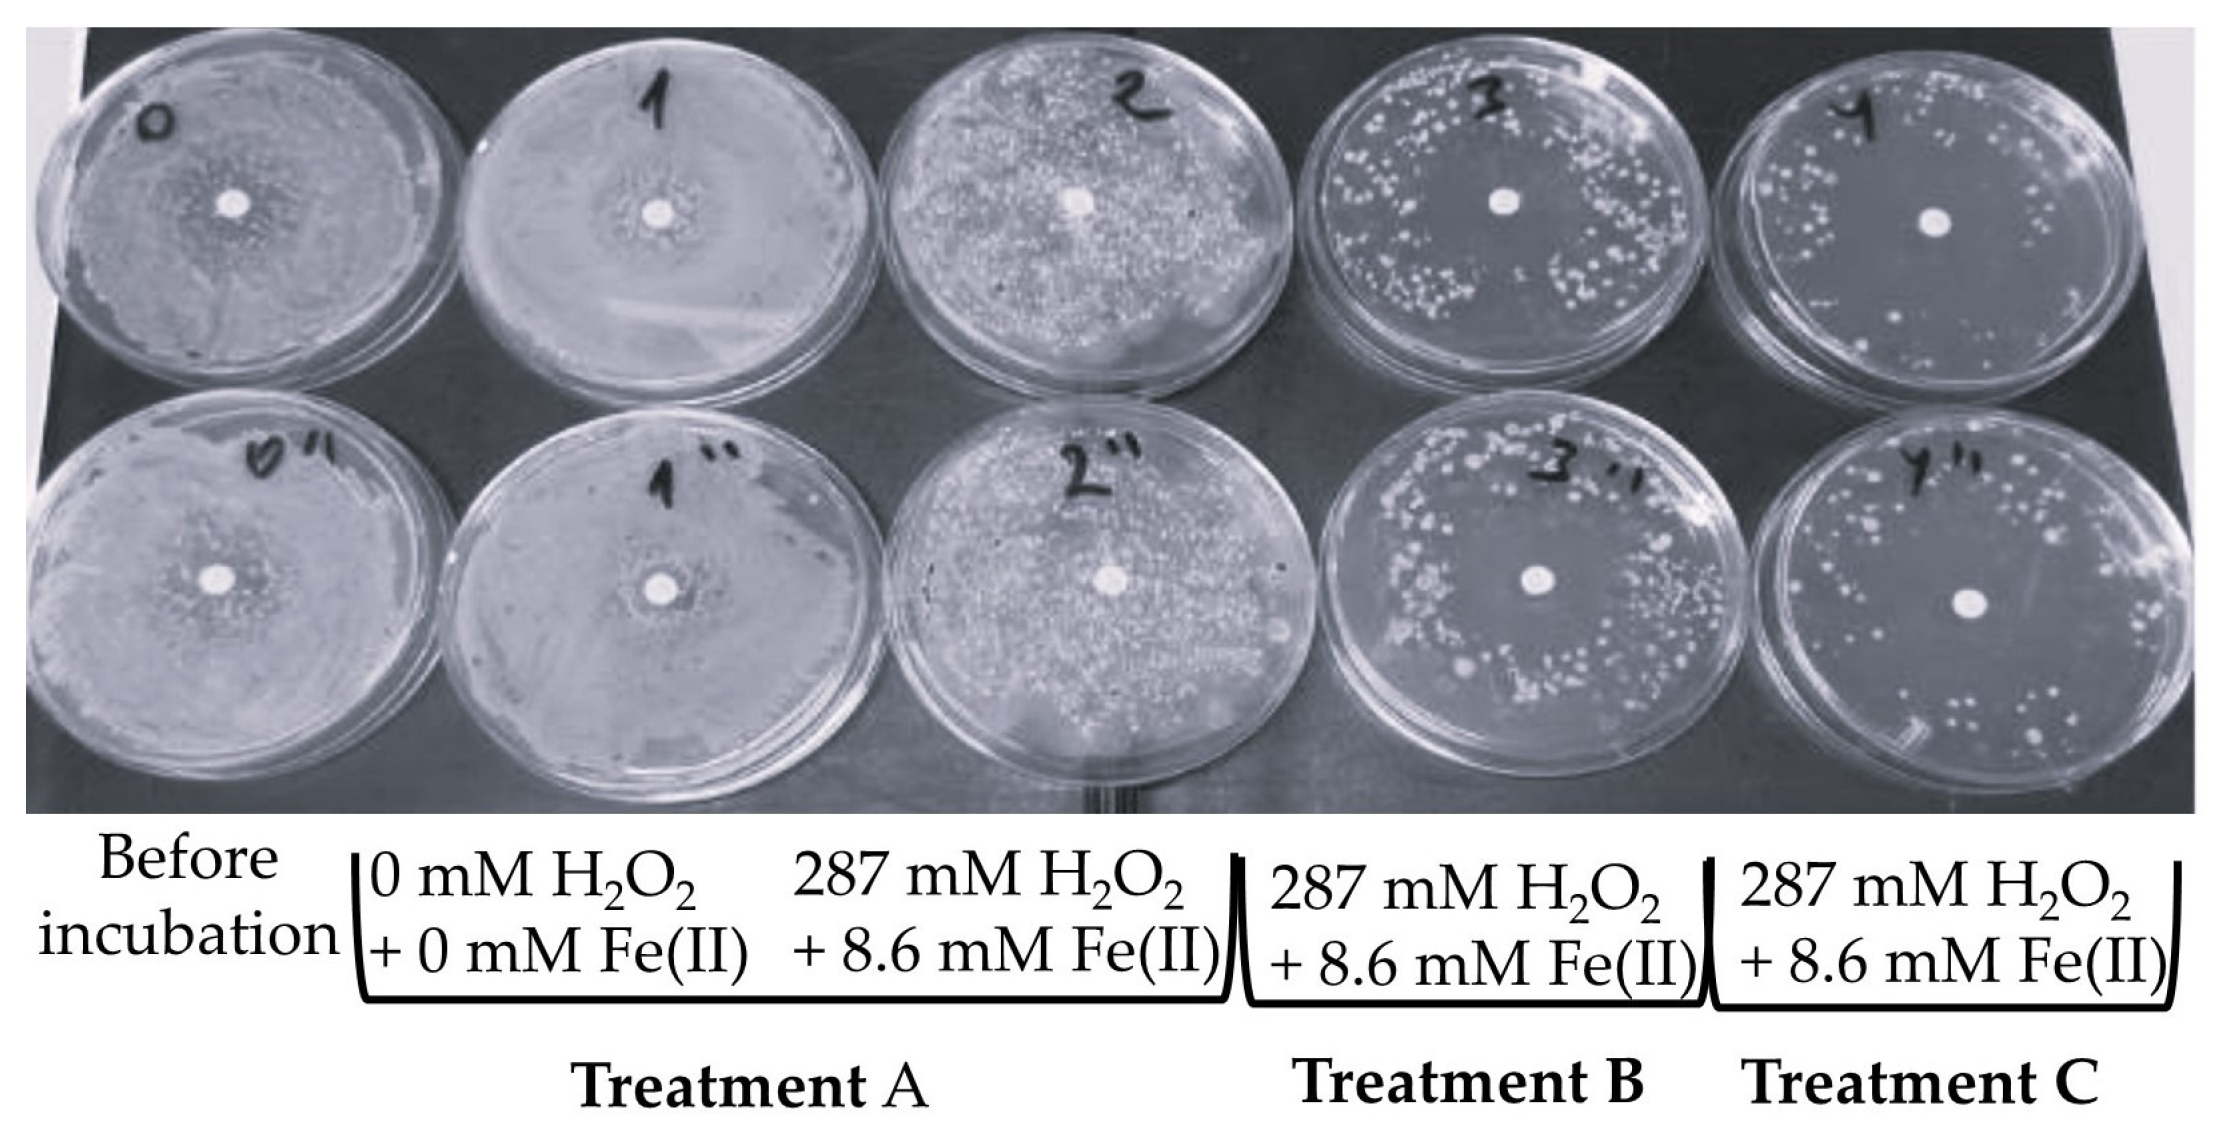
Agronomy 14 03037 g006 Agronomy 14 03037 g006

Disinfection of Activated Sludge by Combination of the Fenton Reagent and Physical Treatment
Abstract
1. Introduction
2. Materials and Methods
2.1. The Source of AS and Its Physicochemical Characteristics
2.2. Optimization of the Fenton Process
2.3. Microbiological Assays
2.4. Biochemical Assays
2.5. Analytical Testing of Pharmaceutical Compounds
2.6. Antimicrobial Resistance of Microorganisms
2.7. Ecotoxicological Evaluation
2.8. Statistical Analysis
3. Results
3.1. Reducing the Number of Culturable Bacteria in AS
3.2. Changes in the FDA Hydrolysis Activity in AS
3.3. Relationship Between Different Endpoints
3.4. Concentration of Pharmaceutical Substances in AS
3.5. Determination of Antimicrobial Resistance in AS
3.5.1. Disk Diffusion Test
3.5.2. Sensititre™ MIC Plates
3.6. Ecotoxicity Testing of AS with T. platyurus
4. Discussion
5. Conclusions
- AS disinfection efficiency was quantified using the log reduction as the standard unit of measurement, and microbial enzymatic activity served as an additional criterion of microbial response towards treatments. Both the log reduction and FDA hydrolysis activity gradually decreased at increasing concentrations of H2O2 and Fe(II) mM; however, not all of these parameters correlated. In frames of the chosen range of reagent concentrations, analysis of the effect of all three treatment types on the log reduction has revealed the optimum combination to be 239 mM H2O2 and 8.6 mM Fe(II). Most probably, Fe(II) concentrations above 8.6 mM would increase the AS disinfection efficiency.
- FDA hydrolysis activity of microorganisms has significantly decreased with increasing Fe(II) concentration in all three treatment methods; a statistically significant (p < 0.05) difference between the three treatment methods with the same reagent concentrations was found mostly between the A and C treatment methods. Correlation between FDA hydrolysis activity and CFU(EMB) count was detected in the data sets with 287 mM H2O2 amended with 4.3 mM, 5.7 mM, 7.2 mM, and 8.6 mM Fe(II), where R2 reached 0.47, 0.90, 0.80, and 0.98, respectively. This finding could be useful for routine monitoring of the disinfection process at comparatively high concentrations of the Fenton reagents.
- Ciprofloxacin concentration in sludge after treatment with 287 mM H2O2, without Fe(II) and additional treatment, has increased from 36.56 to 103.94 mg L−1. On the other hand, in the presence of iron with additional thermal treatment (Treatment B, 287 mM H2O2, 8.6 mM Fe(II)), the concentration of ciprofloxacin in the sludge decreased to 8.54 mg L−1. Removal of pharmaceuticals from AS under tested conditions contributes to the efficiency of the Fenton process for AS treatment.
- Treatment types B and C (287 mM H2O2, 8.6 mM Fe(II)) considerably reduced the number of antimicrobials to which the AS microorganisms were resistant. This effect can be explained by a significant decrease in the CFU number in AS.
- Additional thermal and UV treatments of AS resulted in a dramatic decrease in the number of culturable bacteria and an increase in ecotoxicity for T. platyurus. Obviously, the formation of reactive oxygen species upon the Fenton process affects both bacteria and eukaryotic organisms belonging to the different links of the food chain. More testing is required in terms of life cycle assessment, e.g., phytotoxicity, microbial regrowth, sludge stabilization, dehydration, etc.
Supplementary Materials
Author Contributions
Funding
Data Availability Statement
Acknowledgments
Conflicts of Interest
Appendix A
| Wells | AS, µL | H2O2 | Fe(II) | Amount of Sterile H2O Added, µL | ||||
|---|---|---|---|---|---|---|---|---|
| Amount of 30% H2O2 Added, µL | H2O2, Final Conc., mM | Fe(II), Stock Conc., mM | Amount of Fe(II) Stock Added, µL | Fe(II), Final Conc., mM | ||||
| Plate 1 | A1-A3 | 3000 | 0 | 0 | 0 | 0 | 0.0 | 132 |
| B1-B3 | 3000 | 68 | 191 | 0 | 0 | 0.0 | 64 | |
| C1-C3 | 3000 | 85 | 239 | 0 | 0 | 0.0 | 47 | |
| D1-D3 | 3000 | 102 | 287 | 0 | 0 | 0.0 | 30 | |
| Plate 2 | A1-A3 | 3000 | 0 | 0 | 450 | 30 | 4.3 | 102 |
| B1-B3 | 3000 | 68 | 191 | 450 | 30 | 4.3 | 34 | |
| C1-C3 | 3000 | 85 | 239 | 450 | 30 | 4.3 | 17 | |
| D1-D3 | 3000 | 102 | 287 | 450 | 30 | 4.3 | 0 | |
| Plate 3 | A1-A3 | 3000 | 0 | 0 | 600 | 30 | 5.7 | 102 |
| B1-B3 | 3000 | 68 | 191 | 600 | 30 | 5.7 | 34 | |
| C1-C3 | 3000 | 85 | 239 | 600 | 30 | 5.7 | 17 | |
| D1-D3 | 3000 | 102 | 287 | 600 | 30 | 5.7 | 0 | |
| Plate 4 | A1-A3 | 3000 | 0 | 0 | 750 | 30 | 7.2 | 102 |
| B1-B3 | 3000 | 68 | 191 | 750 | 30 | 7.2 | 34 | |
| C1-C3 | 3000 | 85 | 239 | 750 | 30 | 7.2 | 17 | |
| D1-D3 | 3000 | 102 | 287 | 750 | 30 | 7.2 | 0 | |
| Plate 5 | A1-A3 | 3000 | 0 | 0 | 900 | 30 | 8.6 | 102 |
| B1-B3 | 3000 | 68 | 191 | 900 | 30 | 8.6 | 34 | |
| C1-C3 | 3000 | 85 | 239 | 900 | 30 | 8.6 | 17 | |
| D1-D3 | 3000 | 102 | 287 | 900 | 30 | 8.6 | 0 | |
Appendix B
| H2O2, mM | Fe(II), mM | |||||||||
|---|---|---|---|---|---|---|---|---|---|---|
| 0.0 | 4.3 | 5.7 | 7.2 | 8.6 | ||||||
| AVE | STDEV | AVE | STDEV | AVE | STDEV | AVE | STDEV | AVE | STDEV | |
| Treatment A | ||||||||||
| 0 | 2.07 × 108 | 8.33 × 107 | 2.07 × 108 | 8.33 × 107 | 1.20 × 108 | 6.00 × 107 | 1.13 × 108 | 8.44 × 107 | 5.87 × 107 | 8.78 × 107 |
| 191 | 1.80 × 108 | 1.06 × 108 | 1.80 × 108 | 1.06 × 108 | 1.13 × 108 | 2.31 × 107 | 6.13 × 107 | 8.57 × 107 | 5.55 × 107 | 9.05 × 107 |
| 239 | 1.80 × 108 | 1.06 × 108 | 1.33 × 108 | 1.53 × 108 | 1.20 × 108 | 3.46 × 107 | 6.77 × 107 | 9.78 × 107 | 6.20 × 107 | 8.49 × 107 |
| 287 | 2.00 × 108 | 8.72 × 107 | 2.00 × 108 | 8.72 × 107 | 1.60 × 108 | 8.00 × 107 | 1.20 × 108 | 1.05 × 108 | 1.17 × 108 | 9.18 × 107 |
| Treatment B | ||||||||||
| 0 | 7.47 × 107 | 1.09 × 108 | 7.30 × 107 | 1.10 × 108 | 1.27 × 107 | 6.11 × 106 | 4.53 × 107 | 4.73 × 107 | 8.00 × 106 | 3.46 × 106 |
| 191 | 6.13 × 107 | 8.55 × 107 | 7.93 × 107 | 7.29 × 107 | 6.73 × 107 | 8.03 × 107 | 4.60 × 106 | 6.42 × 106 | 5.04 × 106 | 7.77 × 106 |
| 239 | 1.87 × 108 | 5.03 × 107 | 1.33 × 108 | 1.11 × 108 | 5.17 × 107 | 7.68 × 107 | 2.93 × 105 | 2.69 × 105 | 4.02 × 105 | 3.97 × 105 |
| 287 | 4.51 × 107 | 6.51 × 107 | 8.60 × 107 | 5.89 × 107 | 3.44 × 107 | 5.68 × 107 | 4.40 × 105 | 4.85 × 105 | 5.00 × 104 | 7.79 × 104 |
| Treatment C | ||||||||||
| 0 | 4.76 × 107 | 8.00 × 107 | 7.40 × 106 | 4.50 × 106 | 2.53 × 106 | 3.01 × 106 | 5.35 × 107 | 7.53 × 107 | 2.73 × 106 | 2.83 × 106 |
| 191 | 5.60 × 106 | 5.54 × 106 | 7.00 × 106 | 9.53 × 106 | 4.40 × 105 | 4.85 × 105 | 3.58 × 106 | 5.56 × 106 | 8.67 × 103 | 5.03 × 103 |
| 239 | 1.06 × 107 | 7.69 × 106 | 5.29 × 106 | 7.60 × 106 | 3.05 × 106 | 4.31 × 106 | 6.75 × 105 | 1.15 × 106 | 4.00 × 103 | 0.00 × 100 |
| 287 | 4.20 × 106 | 5.05 × 106 | 1.46 × 107 | 1.15 × 107 | 5.27 × 105 | 7.56 × 105 | 3.93 × 104 | 5.31 × 104 | 6.67 × 103 | 3.06 × 103 |
| H2O2, mM | Fe(II), mM | |||||||||
|---|---|---|---|---|---|---|---|---|---|---|
| 0.0 | 4.3 | 5.7 | 7.2 | 8.6 | ||||||
| AVE | STDEV | AVE | STDEV | AVE | STDEV | AVE | STDEV | AVE | STDEV | |
| Treatment A | ||||||||||
| 0 | 3.30 × 108 | 7.07 × 107 | 2.40 × 108 | 1.98 × 108 | 2.60 × 108 | 1.70 × 108 | 9.10 × 108 | 9.76 × 108 | 3.07 × 107 | 4.14 × 107 |
| 191 | 3.00 × 108 | 2.83 × 107 | 2.80 × 108 | 5.66 × 107 | 2.70 × 108 | 1.56 × 108 | 9.20 × 108 | 9.62 × 108 | 9.80 × 106 | 1.16 × 107 |
| 239 | 3.00 × 108 | 2.83 × 107 | 1.61 × 108 | 2.26 × 108 | 3.00 × 108 | 1.13 × 108 | 8.40 × 107 | 1.07 × 108 | 1.11 × 107 | 1.54 × 107 |
| 287 | 3.00 × 108 | 2.83 × 107 | 2.90 × 108 | 4.24 × 107 | 3.10 × 108 | 9.90 × 107 | 1.40 × 108 | 0.00 × 100 | 7.00 × 107 | 9.89 × 107 |
| Treatment B | ||||||||||
| 0 | 1.70 × 108 | 1.41 × 107 | 2.37 × 108 | 3.15 × 108 | 1.12 × 108 | 1.24 × 108 | 1.10 × 108 | 4.24 × 107 | 5.30 × 107 | 6.65 × 107 |
| 191 | 1.90 × 108 | 7.07 × 107 | 3.60 × 108 | 1.41 × 108 | 1.29 × 108 | 1.57 × 108 | 1.00 × 106 | 0.00 × 100 | 9.20 × 106 | 1.24 × 107 |
| 239 | 2.60 × 108 | 0.00 × 100 | 2.90 × 108 | 2.40 × 108 | 1.30 × 107 | 1.27 × 107 | 2.70 × 105 | 1.84 × 105 | 7.50 × 105 | 9.19 × 105 |
| 287 | 1.40 × 108 | 5.66 × 107 | 2.70 × 108 | 2.69 × 108 | 2.90 × 106 | 1.56 × 106 | 1.80 × 105 | 2.83 × 104 | 1.10 × 105 | 7.07 × 104 |
| Treatment C | ||||||||||
| 0 | 9.00 × 105 | 4.24 × 105 | 7.04 × 107 | 9.84 × 107 | 7.40 × 105 | 9.33 × 105 | 1.10 × 108 | 1.41 × 107 | 1.40 × 106 | 2.83 × 105 |
| 191 | 5.80 × 105 | 5.94 × 105 | 2.10 × 106 | 4.24 × 105 | 1.50 × 105 | 1.56 × 105 | 5.00 × 105 | 1.41 × 105 | 9.00 × 103 | 9.90 × 103 |
| 239 | 1.00 × 105 | 5.66 × 104 | 1.30 × 106 | 7.07 × 105 | 1.13 × 106 | 1.51 × 106 | 3.90 × 104 | 2.97 × 104 | 3.00 × 103 | 4.24 × 103 |
| 287 | 1.20 × 105 | 8.49 × 104 | 5.90 × 106 | 2.97 × 106 | 3.00 × 104 | 1.41 × 104 | 1.00 × 102 | 1.41 × 102 | 5.00 × 102 | 7.07 × 102 |
References
- Europa.eu. Use of Fertilisers in EU Agriculture down 10% in 2022. Available online: https://ec.europa.eu/eurostat/web/products-eurostat-news/w/ddn-20240628-1 (accessed on 24 October 2024).
- Klein, A. An Unfolding Food Crisis: A Perspective from the Fertiliser Industry; UreaKnowHow: Maastricht, The Netherlands, 2024. [Google Scholar]
- Chojnacka, K.; Skrzypczak, D.; Szopa, D.; Izydorczyk, G.; Moustakas, K.; Witek-Krowiak, A. Management of Biological Sewage Sludge: Fertilizer Nitrogen Recovery as the Solution to Fertilizer Crisis. J. Environ. Manag. 2023, 326, 116602. [Google Scholar] [CrossRef]
- Chu, S.; Jacobs, D.F.; Liao, D.; Liang, L.L.; Wu, D.; Chen, P.; Lai, C.; Zhong, F.; Zeng, S. Effects of Landscape Plant Species and Concentration of Sewage Sludge Compost on Plant Growth, Nutrient Uptake, and Heavy Metal Removal. Environ. Sci. Pollut. Res. 2018, 25, 35184–35199. [Google Scholar] [CrossRef] [PubMed]
- Lu, Q.; Liu, J.; He, H.; Liang, Z.; Qiu, R.; Wang, S. Waste Activated Sludge Stimulates in Situ Microbial Reductive Dehalogenation of Organohalide-Contaminated Soil. J. Hazard. Mater. 2021, 411, 125189. [Google Scholar] [CrossRef] [PubMed]
- Sharma, B.; Sarkar, A.; Singh, P.; Singh, R.P. Agricultural Utilization of Biosolids: A Review on Potential Effects on Soil and Plant Grown. Waste Manag. 2017, 64, 117–132. [Google Scholar] [CrossRef]
- Fulazzaky, M.A.; Abdul Gany, A.H. Challenges of Soil Erosion and Sludge Management for Sustainable Development in Indonesia. J. Environ. Manag. 2009, 90, 2387–2392. [Google Scholar] [CrossRef]
- Nguyen, M.D.; Thomas, M.; Surapaneni, A.; Moon, E.M.; Milne, N.A. Beneficial Reuse of Water Treatment Sludge in the Context of Circular Economy. Environ. Technol. Innov. 2022, 28, 102651. [Google Scholar] [CrossRef]
- EPA Biosolids. Available online: https://www.epa.gov/biosolids (accessed on 24 October 2024).
- Martín, A.J.; Shinagawa, T.; Pérez-Ramírez, J. Electrocatalytic Reduction of Nitrogen: From Haber-Bosch to Ammonia Artificial Leaf. Chem 2019, 5, 263–283. [Google Scholar] [CrossRef]
- Oksanen, J.; Pöykiö, R.; Dahl, O. Fertiliser Properties of Wastewater Sludge and Sludge Ash—A Case Study from the Finnish Forest Industry. Ecol. Chem. Eng. S 2023, 30, 63–78. [Google Scholar] [CrossRef]
- Kjerstadius, H.; La Cour Jansen, J.; De Vrieze, J.; Haghighatafshar, S.; Davidsson, Å. Hygienization of Sludge through Anaerobic Digestion at 35, 55 and 60 °C. Water Sci. Technol. 2013, 68, 2234–2239. [Google Scholar] [CrossRef] [PubMed][Green Version]
- Collivignarelli, M.C.; Abbà, A.; Frattarola, A.; Miino, M.C.; Padovani, S.; Katsoyiannis, I.; Torretta, V. Legislation for the Reuse of Biosolids on Agricultural Land in Europe: Overview. Sustainability 2019, 11, 6015. [Google Scholar] [CrossRef]
- Seleiman, M.F.; Santanen, A.; Mäkelä, P.S.A. Recycling Sludge on Cropland as Fertilizer—Advantages and Risks. Resour. Conserv. Recycl. 2020, 155, 104647. [Google Scholar] [CrossRef]
- Karkman, A.; Do, T.T.; Walsh, F.; Virta, M.P.J. Antibiotic-Resistance Genes in Waste Water. Trends Microbiol. 2018, 26, 220–228. [Google Scholar] [CrossRef] [PubMed]
- European Union. Directive (EU) 2018/851 of the European Parliment and of the Council of 30 May 2018 Amending Directive 2008/98/EC on Waste (Text with EEA Relevance). Off. J. Eur. Union L 2018, 150, 109–140. [Google Scholar]
- Wang, G.; Sui, J.; Shen, H.; Liang, S.; He, X.; Zhang, M.; Xie, Y.; Li, L.; Hu, Y. Reduction of Excess Sludge Production in Sequencing Batch Reactor through Incorporation of Chlorine Dioxide Oxidation. J. Hazard. Mater. 2011, 192, 93–98. [Google Scholar] [CrossRef] [PubMed]
- Saby, S.; Djafer, M.; Chen, G.H. Feasibility of Using a Chlorination Step to Reduce Excess Sludge in Activated Sludge Process. Water Res. 2002, 36, 656–666. [Google Scholar] [CrossRef] [PubMed]
- Kim, H.Y.; Jeon, J.; Yu, S.; Lee, M.; Kim, T.H.; Kim, S.D. Reduction of Toxicity of Antimicrobial Compounds by Degradation Processes Using Activated Sludge, Gamma Radiation, and UV. Chemosphere 2013, 93, 2480–2487. [Google Scholar] [CrossRef]
- Valo, A.; Carrère, H.; Delgenès, J.P. Thermal, Chemical and Thermo-Chemical Pre-Treatment of Waste Activated Sludge for Anaerobic Digestion. J. Chem. Technol. Biotechnol. 2004, 79, 1197–1203. [Google Scholar] [CrossRef]
- González, Y.; Gómez, G.; Moeller-Chávez, G.E.; Vidal, G. UV Disinfection Systems for Wastewater Treatment: Emphasis on Reactivation of Microorganisms. Sustainability 2023, 15, 11262. [Google Scholar] [CrossRef]
- Thwaites, B.J.; Short, M.D.; Stuetz, R.M.; Reeve, P.J.; Alvarez Gaitan, J.P.; Dinesh, N.; van den Akker, B. Comparing the Performance of Aerobic Granular Sludge versus Conventional Activated Sludge for Microbial Log Removal and Effluent Quality: Implications for Water Reuse. Water Res. 2018, 145, 442–452. [Google Scholar] [CrossRef]
- Jiang, Y.; Ran, J.; Mao, K.; Yang, X.; Zhong, L.; Yang, C.; Feng, X.; Zhang, H. Recent Progress in Fenton/Fenton-like Reactions for the Removal of Antibiotics in Aqueous Environments. Ecotoxicol. Environ. Saf. 2022, 236, 113464. [Google Scholar] [CrossRef] [PubMed]
- Barhoumi, N.; Oturan, N.; Olvera-Vargas, H.; Brillas, E.; Gadri, A.; Ammar, S.; Oturan, M.A. Pyrite as a Sustainable Catalyst in Electro-Fenton Process for Improving Oxidation of Sulfamethazine. Kinetics, Mechanism and Toxicity Assessment. Water Res. 2016, 94, 52–61. [Google Scholar] [CrossRef]
- Nidheesh, P.V.; Ganiyu, S.O.; Martínez-Huitle, C.A.; Mousset, E.; Olvera-Vargas, H.; Trellu, C.; Zhou, M.; Oturan, M.A. Recent Advances in Electro-Fenton Process and Its Emerging Applications. Crit. Rev. Environ. Sci. Technol. 2023, 53, 887–913. [Google Scholar] [CrossRef]
- Pimentel Prates, M.; de Oliveira Loures Marcionílio, S.M.; Borges Machado, K.; Medeiros de Araújo, D.; Martínez-Huitle, C.A.; Leão Arantes, A.L.; Ferreira da Silva Gadêlha, J.E. Fenton: A Systematic Review of Its Application in Wastewater Treatment. Processes 2023, 11, 2466. [Google Scholar] [CrossRef]
- Pham, T.T.H.; Brar, S.K.; Tyagi, R.D.; Surampalli, R.Y. Optimization of Fenton Oxidation Pre-Treatment for B. Thuringiensis—Based Production of Value Added Products from Wastewater Sludge. J. Environ. Manag. 2010, 91, 1657–1664. [Google Scholar] [CrossRef]
- López-Vinent, N.; Cruz-Alcalde, A.; Giménez, J.; Esplugas, S. Mixtures of Chelating Agents to Enhance Photo-Fenton Process at Natural PH: Influence of Wastewater Matrix on Micropollutant Removal and Bacterial Inactivation. Sci. Total Environ. 2021, 786, 147416. [Google Scholar] [CrossRef] [PubMed]
- Raheem, A.; Sikarwar, V.S.; He, J.; Dastyar, W.; Dionysiou, D.D.; Wang, W.; Zhao, M. Opportunities and Challenges in Sustainable Treatment and Resource Reuse of Sewage Sludge: A Review. Chem. Eng. J. 2018, 337, 616–641. [Google Scholar] [CrossRef]
- Zhang, R.; Liu, X.; Chen, R.; Wang, Z.; Lin, W.; Ngo, H.H.; Nan, J.; Li, G.; Ma, J.; Ding, A. Environmental and Economic Performances of Incorporating Fenton-Based Processes into Traditional Sludge Management Systems. J. Clean. Prod. 2022, 364, 132613. [Google Scholar] [CrossRef]
- Zhang, H.; Qi, H.Y.; Zhang, Y.L.; Ran, D.D.; Wu, L.Q.; Wang, H.F.; Zeng, R.J. Effects of Sewage Sludge Pretreatment Methods on Its Use in Agricultural Applications. J. Hazard. Mater. 2022, 428, 128213. [Google Scholar] [CrossRef] [PubMed]
- Ziembowicz, S.; Kida, M. Limitations and Future Directions of Application of the Fenton-like Process in Micropollutants Degradation in Water and Wastewater Treatment: A Critical Review. Chemosphere 2022, 296, 134041. [Google Scholar] [CrossRef] [PubMed]
- Tao, Y. Advanced Oxidation Processes for Water Purification Applications. Int. J. Innov. Entrep. 2022, 1, 2. [Google Scholar] [CrossRef]
- Schnurer, J.; Rosswall, T. Fluorescein Diacetate Hydrolysis as a Measure of Total Microbial Activity in Soil and Litter. Appl. Environ. Microbiol. 1982, 43, 1256–1261. [Google Scholar] [CrossRef]
- Derringer, G.; Suich, R. Simultaneous Optimization of Several Response Variables. J. Qual. Technol. 1980, 12, 214–219. [Google Scholar] [CrossRef]
- Kuhn, M. Desirability: Function Optimization and Ranking via Desirability Functions. Available online: https://cran.r-project.org/web/packages/desirability/desirability.pdf (accessed on 15 October 2024).
- R Core Team. The R Project for Statistical Computing. Available online: https://www.r-project.org/ (accessed on 28 October 2024).
- Wickham, H. Ggplot2: Elegant Graphics for Data Analysis, 2nd ed.; Springer: Cham, Switzerland, 2016. [Google Scholar] [CrossRef]
- Wickham, H.; Averick, M.; Bryan, J.; Chang, W.; McGowan, L.; François, R.; Grolemund, G.; Hayes, A.; Henry, L.; Hester, J.; et al. Welcome to the Tidyverse. J. Open Source Softw. 2019, 4, 1686. [Google Scholar] [CrossRef]
- Kumar, A.; Rana, A.; Sharma, G.; Naushad, M.; Dhiman, P.; Kumari, A.; Stadler, F.J. Recent Advances in Nano-Fenton Catalytic Degradation of Emerging Pharmaceutical Contaminants. J. Mol. Liq. 2019, 290, 111177. [Google Scholar] [CrossRef]
- Kazimierowicz, J.; Dębowski, M.; Zieliński, M. Effect of Pharmaceutical Sludge Pre-Treatment with Fenton/Fenton-like Reagents on Toxicity and Anaerobic Digestion Efficiency. Int. J. Environ. Res. Public Health 2023, 20, 271. [Google Scholar] [CrossRef] [PubMed]
- Lee, Y.Y.; Fan, C.; Haque, F. Hybrid Combination of Advanced Oxidation and Biological Processes for the Micropollutant Removal of Carbamazepine. NPJ Clean Water 2022, 5, 60. [Google Scholar] [CrossRef]
- Atay, Ş.; Akbal, F. Classification and Effects of Sludge Disintegration Technologies Integrated Into Sludge Handling Units: An Overview. Clean 2016, 44, 1198–1213. [Google Scholar] [CrossRef]
- Racyte, J.; Bernard, S.; Paulitsch-Fuchs, A.H.; Yntema, D.R.; Bruning, H.; Rijnaarts, H.H.M. Alternating Electric Fields Combined with Activated Carbon for Disinfection of Gram Negative and Gram Positive Bacteria in Fluidized Bed Electrode System. Water Res. 2013, 47, 6395–6405. [Google Scholar] [CrossRef] [PubMed]
- Loraine, G.; Chahine, G.; Hsiao, C.T.; Choi, J.K.; Aley, P. Disinfection of Gram-Negative and Gram-Positive Bacteria Using DynaJets® Hydrodynamic Cavitating Jets. Ultrason. Sonochem. 2012, 19, 710–717. [Google Scholar] [CrossRef] [PubMed]
- Zhang, J.; Su, P.; Chen, H.; Qiao, M.; Yang, B.; Zhao, X. Impact of Reactive Oxygen Species on Cell Activity and Structural Integrity of Gram-Positive and Gram-Negative Bacteria in Electrochemical Disinfection System. Chem. Eng. J. 2023, 451, 138879. [Google Scholar] [CrossRef]
- He, J.; Zheng, Z.; Lo, I.M.C. Different Responses of Gram-Negative and Gram-Positive Bacteria to Photocatalytic Disinfection Using Solar-Light-Driven Magnetic TiO2-Based Material, and Disinfection of Real Sewage. Water Res. 2021, 207, 117816. [Google Scholar] [CrossRef] [PubMed]
- Goel, R.; Mino, T.; Satoh, H.; Matsuo, T. Enzyme Activities under Anaerobic and Aerobic Conditions in Activated Sludge Sequencing Batch Reactor. Water Res. 1998, 32, 2081–2088. [Google Scholar] [CrossRef]
- Hassard, F.; Biddle, J.; Harnett, R.; Stephenson, T. Microbial Extracellular Enzyme Activity Affects Performance in a Full-Scale Modified Activated Sludge Process. Sci. Total Environ. 2018, 625, 1527–1534. [Google Scholar] [CrossRef] [PubMed]
- Jayapal, V.; Sharmila, K.M.; Selvibai, G.; Thyagarajan, S.P.; Shanmugasundaram Subramanian, N.S. Fluorescein Diacetate and Ethidium Bromide Staining to Determine the Viability of Mycobacterium Smegmatis and Escherichia Coli. Lepr. Rev. 1991, 62, 310–314. [Google Scholar] [CrossRef] [PubMed]
- Chrzanowski, T.H.; Crotty, R.D.; Hubbard, J.G.; Welch, R.P. Applicability of the Fluorescein Diacetate Method of Detecting Active Bacteria in Freshwater. Microb. Ecol. 1984, 10, 179–185. [Google Scholar] [CrossRef]
- Bolesta, W.; Głodniok, M.; Styszko, K. From Sewage Sludge to the Soil—Transfer of Pharmaceuticals: A Review. Int. J. Environ. Res. Public Health 2022, 19, 10246. [Google Scholar] [CrossRef]
- Park, J.; Kim, C.; Hong, Y.; Lee, W.; Chung, H.; Jeong, D.H.; Kim, H. Distribution and Removal of Pharmaceuticals in Liquid and Solid Phases in the Unit Processes of Sewage Treatment Plants. Int. J. Environ. Res. Public. Health. 2020, 17, 687. [Google Scholar] [CrossRef]
- Muter, O.; Perkons, I.; Svinka, V.; Svinka, R.; Bartkevics, V. Distinguishing the Roles of Carrier and Biofilm in Filtering Media for the Removal of Pharmaceutical Compounds from Wastewater. Process Saf. Environ. Prot. 2017, 111, 462–474. [Google Scholar] [CrossRef]
- Alfonso-Muniozguren, P.; Serna-Galvis, E.A.; Bussemaker, M.; Torres-Palma, R.A.; Lee, J. A Review on Pharmaceuticals Removal from Waters by Single and Combined Biological, Membrane Filtration and Ultrasound Systems. Ultrason. Sonochem. 2021, 76, 105656. [Google Scholar] [CrossRef]
- Reinholds, I.; Muter, O.; Perkons, I.; Pugajeva, I.; Rusko, J.; Bartkevics, V. Determination of Pharmaceutical Residues and Assessment of Their Removal Efficiency at the Daugavgriva Municipal Wastewater Treatment Plant in Riga. Water Sci. Technol. 2017, 75, 387–396. [Google Scholar] [CrossRef]
- Molnarova, L.; Halesova, T.; Tomesova, D.; Vaclavikova, M.; Bosakova, Z. Monitoring Pharmaceuticals and Personal Care Products in Healthcare Effluent Wastewater Samples and the Effectiveness of Drug Removal in Wastewater Treatment Plants Using the UHPLC-MS/MS Method. Molecules 2024, 29, 1480. [Google Scholar] [CrossRef] [PubMed]
- Tran, N.H.; Reinhard, M.; Gin, K.Y.H. Occurrence and Fate of Emerging Contaminants in Municipal Wastewater Treatment Plants from Different Geographical Regions—A Review. Water Res 2018, 133, 182–207. [Google Scholar] [CrossRef] [PubMed]
- Morais, S.A.; Delerue-Matos, C.; Gabarrell, X. An Uncertainty and Sensitivity Analysis Applied to the Prioritisation of Pharmaceuticals as Surface Water Contaminants from Wastewater Treatment Plant Direct Emissions. Sci. Total Environ. 2014, 490, 342–350. [Google Scholar] [CrossRef]
- Korzeniewska, E.; Harnisz, M. Relationship between Modification of Activated Sludge Wastewater Treatment and Changes in Antibiotic Resistance of Bacteria. Sci. Total Environ. 2018, 639, 304–315. [Google Scholar] [CrossRef]
- Hou, J.; Chen, Z.; Gao, J.; Xie, Y.; Li, L.; Qin, S.; Wang, Q.; Mao, D.; Luo, Y. Simultaneous Removal of Antibiotics and Antibiotic Resistance Genes from Pharmaceutical Wastewater Using the Combinations of Up-Flow Anaerobic Sludge Bed, Anoxic-Oxic Tank, and Advanced Oxidation Technologies. Water Res. 2019, 159, 511–520. [Google Scholar] [CrossRef] [PubMed]
- Shoji, R.; Mohri, S.; Sakai, Y.; Yamada, M. Ecotoxicity Assessment of Sludge and Leaching Test Eluates of Sludge. J. Environ. Sci. Health A Toxic/Hazard. Subst. Environ. Eng. 2008, 43, 1042–1047. [Google Scholar] [CrossRef] [PubMed]
- Dries, J.; Daens, D.; Geuens, L.; Blust, R. Evaluation of Acute Ecotoxicity Removal from Industrial Wastewater Using a Battery of Rapid Bioassays. Water Sci. Technol. 2014, 70, 2056–2061. [Google Scholar] [CrossRef]
- Santos, A.F.; Alvarenga, P.; Gando-Ferreira, L.M.; Quina, M.J. Agronomic Valorization of Sewage Sludge: The Potential of Thermal Drying to Achieve Sanitation and Biological Stability. Sustain. Chem. Pharm. 2022, 27, 100646. [Google Scholar] [CrossRef]
- Jorge, N.; Teixeira, A.R.; Lucas, M.S.; Peres, J.A. Agro-Industrial Wastewater Treatment with Acacia Dealbata Coagulation/Flocculation and Photo-Fenton-Based Processes. Recycling 2022, 7, 54. [Google Scholar] [CrossRef]
- Nesterov, D.; Barrera-Martínez, I.; Martínez-Sánchez, C.; Sandoval-González, A.; Bustos, E. Approaching the Circular Economy: Biological, Physicochemical, and Electrochemical Methods to Valorize Agro-Industrial Residues, Wastewater, and Industrial Wastes. J. Environ. Chem. Eng. 2024, 12, 113335. [Google Scholar] [CrossRef]

| (A) | ||||||||||||||||
| H2O2, mM | Treatment A | Treatment B | Treatment C | |||||||||||||
| Fe(II), mM | ||||||||||||||||
| 0 | 4.3 | 5.7 | 7.2 | 8.6 | 0 | 4.3 | 5.7 | 7.2 | 8.6 | 0 | 4.3 | 5.7 | 7.2 | 8.6 | ||
| 0 | - | 0.00 | 0.24 | 0.26 | 0.55 | 0.44 | 0.45 | 1.21 | 0.66 | 1.41 | 0.64 | 1.45 | 1.91 | 0.59 | 1.88 | |
| 191 | 0.06 | 0.06 | 0.26 | 0.53 | 0.57 | 0.53 | 0.42 | 0.49 | 1.65 | 1.61 | 1.57 | 1.47 | 2.67 | 1.76 | 4.38 | |
| 239 | 0.06 | 0.19 | 0.24 | 0.49 | 0.52 | 0.04 | 0.19 | 0.60 | 2.85 | 2.71 | 1.29 | 1.59 | 1.83 | 2.49 | 4.71 | |
| 287 | 0.01 | 0.01 | 0.11 | 0.24 | 0.25 | 0.66 | 0.38 | 0.78 | 2.67 | 3.62 | 1.69 | 1.15 | 2.59 | 3.72 | 4.49 | |
| (B) | ||||||||||||||||
| H2O2, mM | Treatment A | Treatment B | Treatment C | |||||||||||||
| Fe(II), mM | ||||||||||||||||
| 0 | 4.3 | 5.7 | 7.2 | 8.6 | 0 | 4.3 | 5.7 | 7.2 | 8.6 | 0 | 4.3 | 5.7 | 7.2 | 8.6 | ||
| 0 | - | 0.14 | 0.10 | −0.44 | 1.03 | 0.29 | 0.14 | 0.47 | 0.48 | 0.79 | 2.56 | 0.67 | 2.65 | 0.48 | 2.37 | |
| 191 | 0.04 | 0.07 | 0.09 | −0.45 | 1.53 | 0.24 | −0.04 | 0.41 | 2.52 | 1.55 | 2.76 | 2.20 | 3.34 | 2.82 | 4.56 | |
| 239 | 0.04 | 0.31 | 0.04 | 0.59 | 1.47 | 0.10 | 0.06 | 1.40 | 3.09 | 2.64 | 3.52 | 2.40 | 2.47 | 3.93 | 5.04 | |
| 287 | 0.04 | 0.06 | 0.03 | 0.37 | 0.67 | 0.37 | 0.09 | 2.06 | 3.26 | 3.48 | 3.44 | 1.75 | 4.04 | 6.52 | 5.82 | |
| Outputs | Compounds and Desirability Score | Treatment A | Treatment B | Treatment C | All Treatments |
|---|---|---|---|---|---|
| H2O2, mM | 191 | 287 | 239 | 239 |
| Fe(II), mM | 8.6 | 8.6 | 8.6 | 8.6 | |
| Desirability score | 1.0000000 | 1.0000000 | 0.9999868 | 0.9999960 (Treatment C) | |
| H2O2, mM | 191 | 287 | 287 | 287 |
| Fe(II), mM | 8.6 | 8.6 | 8.6 | 8.6 | |
| Desirability score | 1.0000000 | 1.0000000 | 0.9999822 | 0.9998240 (Treatment B) |
| Antimicrobials | Concentration of Antimicrobials, µg mL−1 | Antimicrobial Resistance | |||
|---|---|---|---|---|---|
| AS-A (0 mM H2O2, 0 mM Fe(II) | AS-B (287 mM H2O2, 8.6 mM Fe(II) | AS-C (287 mM H2O2, 8.6 mM Fe(II) | |||
| TAZ | Ceftazidime | 1–16 | + | - | - |
| GEN | Gentamicin | 1–8 | + | - | - |
| PIP | Piperacilin | 8–64 | - | - | - |
| P/T4 | Piperacilin/tazobactam constant 4 | 8/4–64/4 | - | - | - |
| AMI | Amikacin | 4–32 | + | - | - |
| FEP | Cefepime | 2–16 | + | + | - |
| FOP | Cefoperazone | 4–32 | + | + | - |
| LOM | Lomefloxacin | 0.5–4 | + | + | + |
| IMI | Imipenem | 1–8 | + | + | - |
| TIM2 | Ticarcillin/clavulanic acid constant 2 | 16/2–128/2 | + | + | - |
| TIC | Ticarcllin | 8–64 | + | - | - |
| SXT | Trimethoprim/sulfamethoxazole | 0.5/9.5–4/76 | + | - | - |
| A/S2 | Ampicillin/sulbactam 2:1 ratio | 2/1–16/8 | - | - | - |
| FOT | Cefotaxime | 4–32 | + | + | + |
| CHL | Chloramphenicol | 2–16 | + | - | - |
| TOB | Tobramycin | 1–8 | + | - | - |
| AXO | Ceftriaxone | 4–32 | + | + | - |
| LEVO | Levofloxacine | 0.5–4 | + | + | - |
| FIS | Sulfisoxazole | 256 | - | - | - |
| CAR | Carbenicillin | 32–256 | + | - | - |
| AZT | Aztreonam | 2–16 | + | - | + |
| CIP | Ciprofloxacin | 0.25–2 | - | - | - |
| TET | Tetracycline | 1–8 | + | - | - |
| NEG | Negative control | - | - | - | - |
| POS | Positive control | - | + | + | + |
Disclaimer/Publisher’s Note: The statements, opinions and data contained in all publications are solely those of the individual author(s) and contributor(s) and not of MDPI and/or the editor(s). MDPI and/or the editor(s) disclaim responsibility for any injury to people or property resulting from any ideas, methods, instructions or products referred to in the content. |
© 2024 by the authors. Licensee MDPI, Basel, Switzerland. This article is an open access article distributed under the terms and conditions of the Creative Commons Attribution (CC BY) license (https://creativecommons.org/licenses/by/4.0/).
Share and Cite
Blumfelde, M.; Dēliņa, A.; Puzane, K.; Bartkevičs, V.; Muter, O. Disinfection of Activated Sludge by Combination of the Fenton Reagent and Physical Treatment. Agronomy 2024, 14, 3037. https://doi.org/10.3390/agronomy14123037
Blumfelde M, Dēliņa A, Puzane K, Bartkevičs V, Muter O. Disinfection of Activated Sludge by Combination of the Fenton Reagent and Physical Treatment. Agronomy. 2024; 14(12):3037. https://doi.org/10.3390/agronomy14123037
Chicago/Turabian StyleBlumfelde, Māra, Aija Dēliņa, Kristina Puzane, Vadims Bartkevičs, and Olga Muter. 2024. "Disinfection of Activated Sludge by Combination of the Fenton Reagent and Physical Treatment" Agronomy 14, no. 12: 3037. https://doi.org/10.3390/agronomy14123037
APA StyleBlumfelde, M., Dēliņa, A., Puzane, K., Bartkevičs, V., & Muter, O. (2024). Disinfection of Activated Sludge by Combination of the Fenton Reagent and Physical Treatment. Agronomy, 14(12), 3037. https://doi.org/10.3390/agronomy14123037

